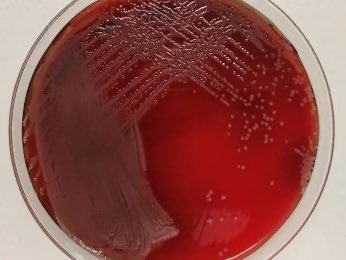
scientiasnet tweet media

📃Jorge Comendador, Ester López-Fernández, Carlos Caballero, José Villaseñor-Camacho, Javier Llanos, Residual biomass-derived carbon materials for fabrication of non-enzymatic glucose sensors, Biomass and Bioenergy, Vol 209, 2026.
doi.org/10.1016/j.biom…
Español